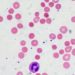

Preterm birth associated with differences in optic disc morphology in adulthood
1. In a cohort of approximately 750 eyes of 400 adults, vertical cup-to-disc ratio (VCDR) was significantly increased for individuals born before 28 weeks compared to those born at full term.
2. History of retinopathy of prematurity (ROP) was not associated with a difference in VCDR.
Evidence Rating Level: 2 (Good)
Study Rundown: Retinopathy of prematurity (ROP) is a common complication of preterm birth. Initial hyperoxia due to oxygen supplementation and neonatal changes induces dysregulated vascular proliferation in the retina. Outcomes of ROP beyond early childhood are currently poorly understood. The Gutenberg Prematurity Eye Study examined a cohort of German adults born prematurely with and without a history of ROP. In this study, optic nerve head morphology was assessed as a marker for enduring central nervous system changes as well as potential predisposition to glaucoma. Optic disc metrics were measured using fundus photography then compared between 74 eyes of individuals born preterm with ROP, 413 without ROP, and 256 of controls born at full-term. Vertical cup-to-disc ratio (VCDR) was significantly higher in patients born at or before 28 weeks gestation without ROP and with untreated ROP than in the control group. The 5 patients with ROP who had been treated with laser or cryo-coagulation had significantly smaller VCDR than controls and were more likely to have torted discs, although interpretation is limited by the small subgroup size. In an adjusted model, lower gestational age, birth weight, and birth weight percentile were all significantly associated with decreased VCDR. The occurrence of ROP was not associated with any difference in VCDR. Though fewer patients with ROP were included, this study indicates that extreme prematurity is associated with increased cup-to-disk ratio while ROP itself is not. It seems possible that some portion of the patients born before 28 weeks suffered from undiagnosed ROP, leading to a confounding effect. Further study of the implications of these morphological differences for glaucoma risk is called for, especially as the percentage of the population born premature and extremely premature increases.
Click to read the study in AJO
Relevant Reading: Retinopathy of prematurity
In-Depth [retrospective cohort]: Adults aged 18 to 52 years who had been born at a single center were included. Controls born at full-term, defined as 37 weeks or later, were not demographically matched to preterm subjects. Non-dilated fundus photographs were taken at 30° and 45° to the optic nerve head. Optic disc dimensions were measured manually using ImageJ and corrected for ocular magnification. Discs with a torsion angle greater than 15° were considered torted, while discs with a ratio <0.8 between short and long diameters were considered tilted. Macula-disc angle did not differ between most of the groups stratified by gestational age. Analysis for associations with VCDR was performed after adjusting for age, sex, spherical equivalent, and optic disc dimensions. No significant association between VCDR and potential prenatal or perinatal risk factors, including preeclampsia, placental insufficiency, or maternal smoking, was observed. The torsion angle was significantly lower in patients whose mothers had preeclampsia and in patients who received treatment for ROP.
Image: PD
©2022 2 Minute Medicine, Inc. All rights reserved. No works may be reproduced without expressed written consent from 2 Minute Medicine, Inc. Inquire about licensing here. No article should be construed as medical advice and is not intended as such by the authors or by 2 Minute Medicine, Inc.